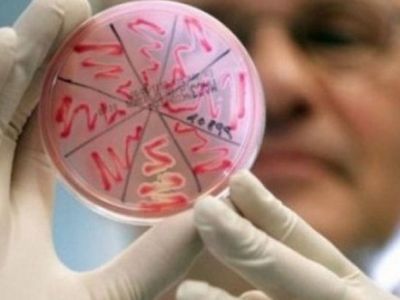
Источник фото: racurs.ua

В Тюменской области в 2023 году более 400 человек заразились опасными венерическими заболеваниями. Среди больных 11 детей, сообщил 10 июня корреспондент Каспаров.Ru со ссылкой на пресс-службу регионального Роспотребнадзора.
В ведомстве уточнили, что в 2023 году насчитывается 155 случаев заражения сифилисом и больше 250 случаев гонореи, среди детей зарегистрировано три случая заболевания сифилисом.
У тюменцев до 14 лет заболевания не выявлено. В возрасте от 15 до 17 лет насчитывалось восемь случаев гонококковой инфекции.
Основная доля заболевших гонореей приходилась на Тюмень, а сифилисом — на Тюмень и Тюменский район.